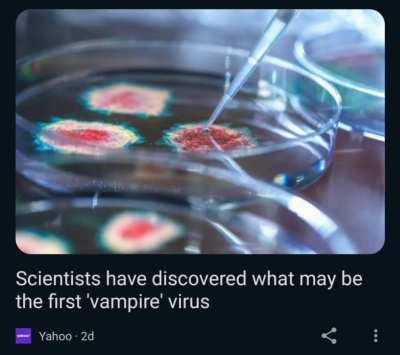
A

DramaticText
DramaticText
Browse Other Categories
- AmericanHistory
- awesomefattymoments
- Boniver8circlejerk
- boottimemasterrace
- Canthaveshitindetroit
- ChocolateDreamhouse
- Comparison
- dankmemer
- Epicgamerpics
- Fardbardisles
- fizzmains
- FunnyAtheistMemes
- IndieDev
- jihadirony2
- LeoobalysPictures
- MartletAppreciation
- memes
- modelrockets
- nikkiflag
- NudesOF2023
- PaigeJordaeee
- ShitpostRun
- u_DefPrxmiseFreakz
- u_Good-Class-1311
- u_Grocery_Worldly